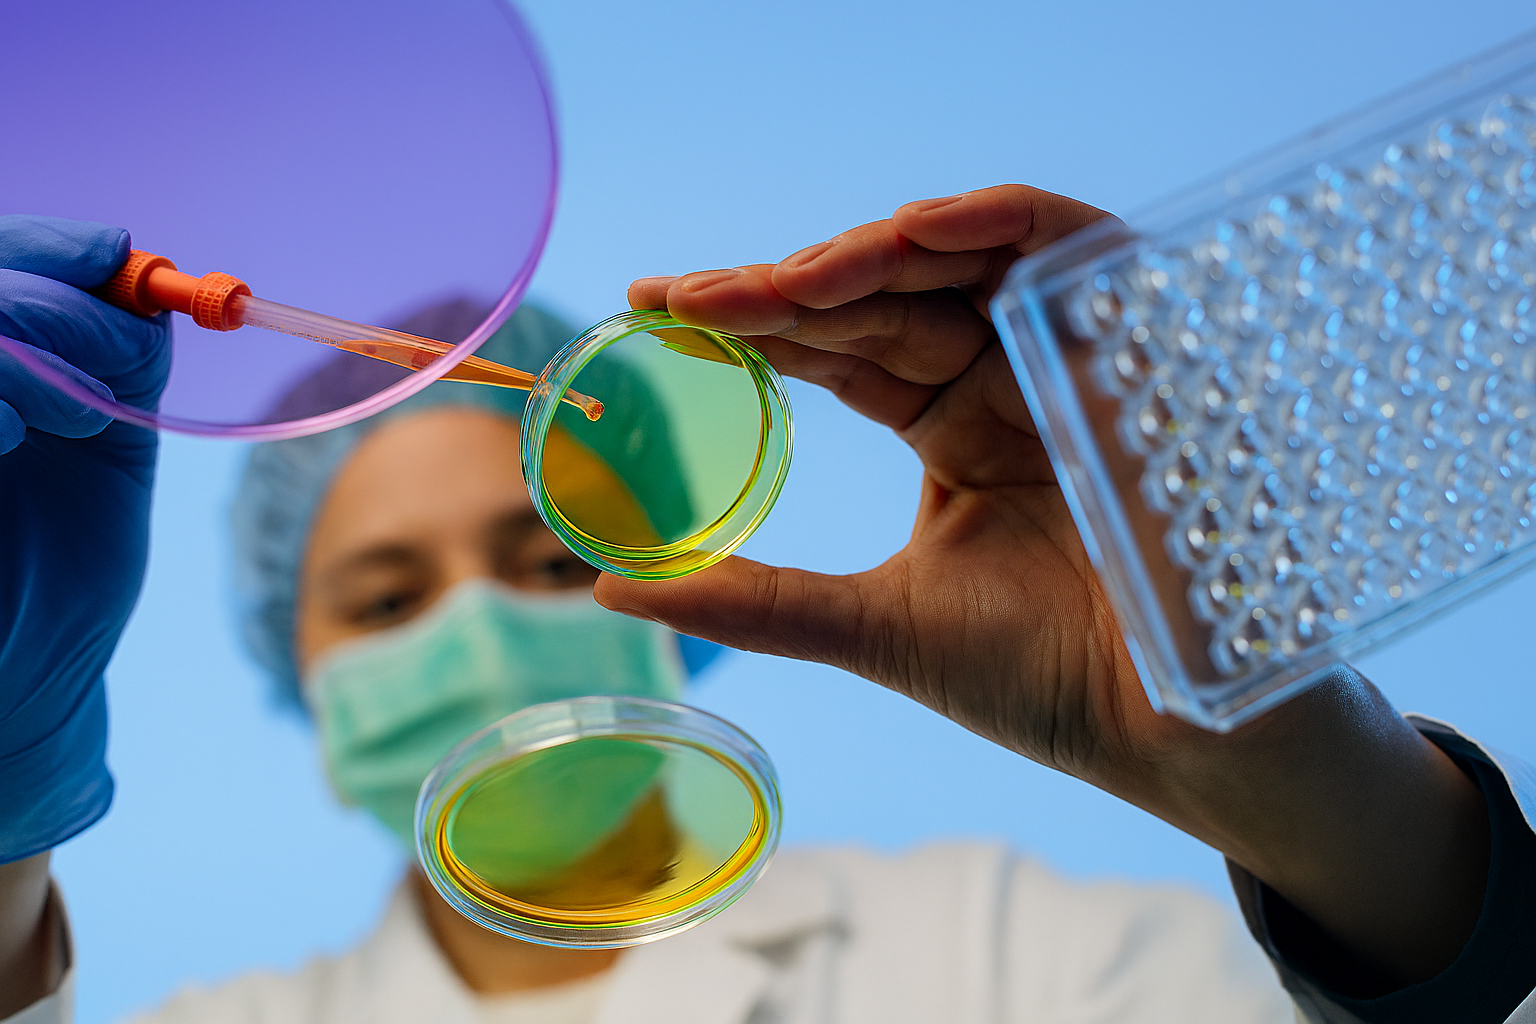

- Home
- BIOTECHNOLÓGIE Bc.
Bakalársky program Biotechnológie pripravuje odborníkov so základnými vedomosťami z biológie, biochémie, mikrobiológie, molekulárnej biológie a biochemických technológií. Študenti sa učia pracovať s modernými analytickými, mikrobiálnymi a molekulárno‑biologickými metódami, kultivovať mikroorganizmy či bunkové kultúry a hodnotiť kvalitu bioproduktov. Program zdôrazňuje prepojenie na prax, biotechnologické procesy a aplikácie v potravinárstve, poľnohospodárstve, environmentálnych a priemyselných biotechnológiách. Absolvent je pripravený pôsobiť ako laboratórny technik, procesný technik či odborný pracovník v biotechnologickej výrobe alebo pokračovať v inžinierskom štúdiu.
Forma štúdia
- denná prezenčná / denná kombinovaná
Dĺžka štúdia
- 3 roky
Jazyk
- slovenský
PROFILOVÉ PREDMETY
Aplikovaná mikrobiológia
Anorganická chémia
Biochemické technológie
Biomolekuly a metabolizmus
Funkčná biológia rastlín
Fyziológia živočíchov
Kvasné technológie
Laboratórne metódy v biotechnológiách
Laboratórne metódy v mikrobiológii
Molekulárna biológia
Pokročilé laboratórne metódy v biotechnológiách
Všeobecná mikrobiológia
Základy biotechnológií
Základy genomiky a proteomiky
Úvod do štúdia biotechnológií
UPLATNENIE ABSOLVENTA
Absolventi majú dostatok teoretických vedomostí a praktických zručností, čo im umožňuje riadiť čiastkové technologické procesy a operácie. Sú schopní vykonávať kontroly v laboratóriách, podieľať sa na výskumnej činnosti a riadení výrobných biotechnologických procesov. Absolventi sú odborne spôsobilí vykonávať práce spojené s produkciou, izoláciou, separáciou a purifikáciou produktov, hodnotením ich kvality s použitím moderných fyzikálno – chemických, analytických, mikrobiologických a molekulárno-biologických metód. Dokážu vykonávať práce na technických a obchodných pozíciách v oblasti biotechnológií, spolupracovať s manažérmi výrobných organizácií a so špecialistami iných profesií v oblasti inovácie technologických liniek a výrobkov, ako aj v oblasti hodnotenia akostných parametrov kvality a marketingu. Sú schopní vykonávať prácu manažéra pre predaj v oblasti molekulárnej biológie a biotechnológie. Sú schopní prezentovať produkty, propagovať a sprostredkovať predaj tovarov a služieb spoločnosti, ktorú zastupujú. Dokážu komunikovať s existujúcimi aj potenciálnymi obchodnými partnermi a poskytnúť im odborné poradenstvo.
KONTAKT
Fakulta biotechnológie a potravinárstva SPU v Nitre
Tr. A. Hlinku 2, 949 76 Nitra
037/641 5384, 037/641 5386